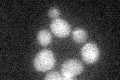
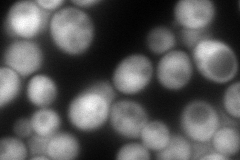
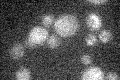

View description
Pyrimidine nucleotidase; overexpression suppresses the 6-AU sensitivity of transcription elongation factor S-II, as well as resistance to other pyrimidine derivatives
Localization:
Intensity:
Fold change:
Significance:
-
C’ GFP library in SD
cytosol17.71 -
N' NOP1pr-GFP in SD

cytosol131.524 -
N' TEF2pr-mCherry in SD
cytosol211.386 -
N' NATIVEpr-GFP in SD

below threshold15.5899 -
N' TEF2pr-VC and Cyto-VN in SD

cytosol64.2773 -
C’ GFP library in SD+DTT

cytosol17.961.01No -
C’ GFP library in SD+H2O2

cytosol17.160.96No -
C’ GFP library in Starvation Media
cytosol16.310.92No -
C’ GFP library on the background of Pup2-DaMP

cytosol -
C’ GFP library on the background of CCT mutant

cytosol19.08661.07696No
